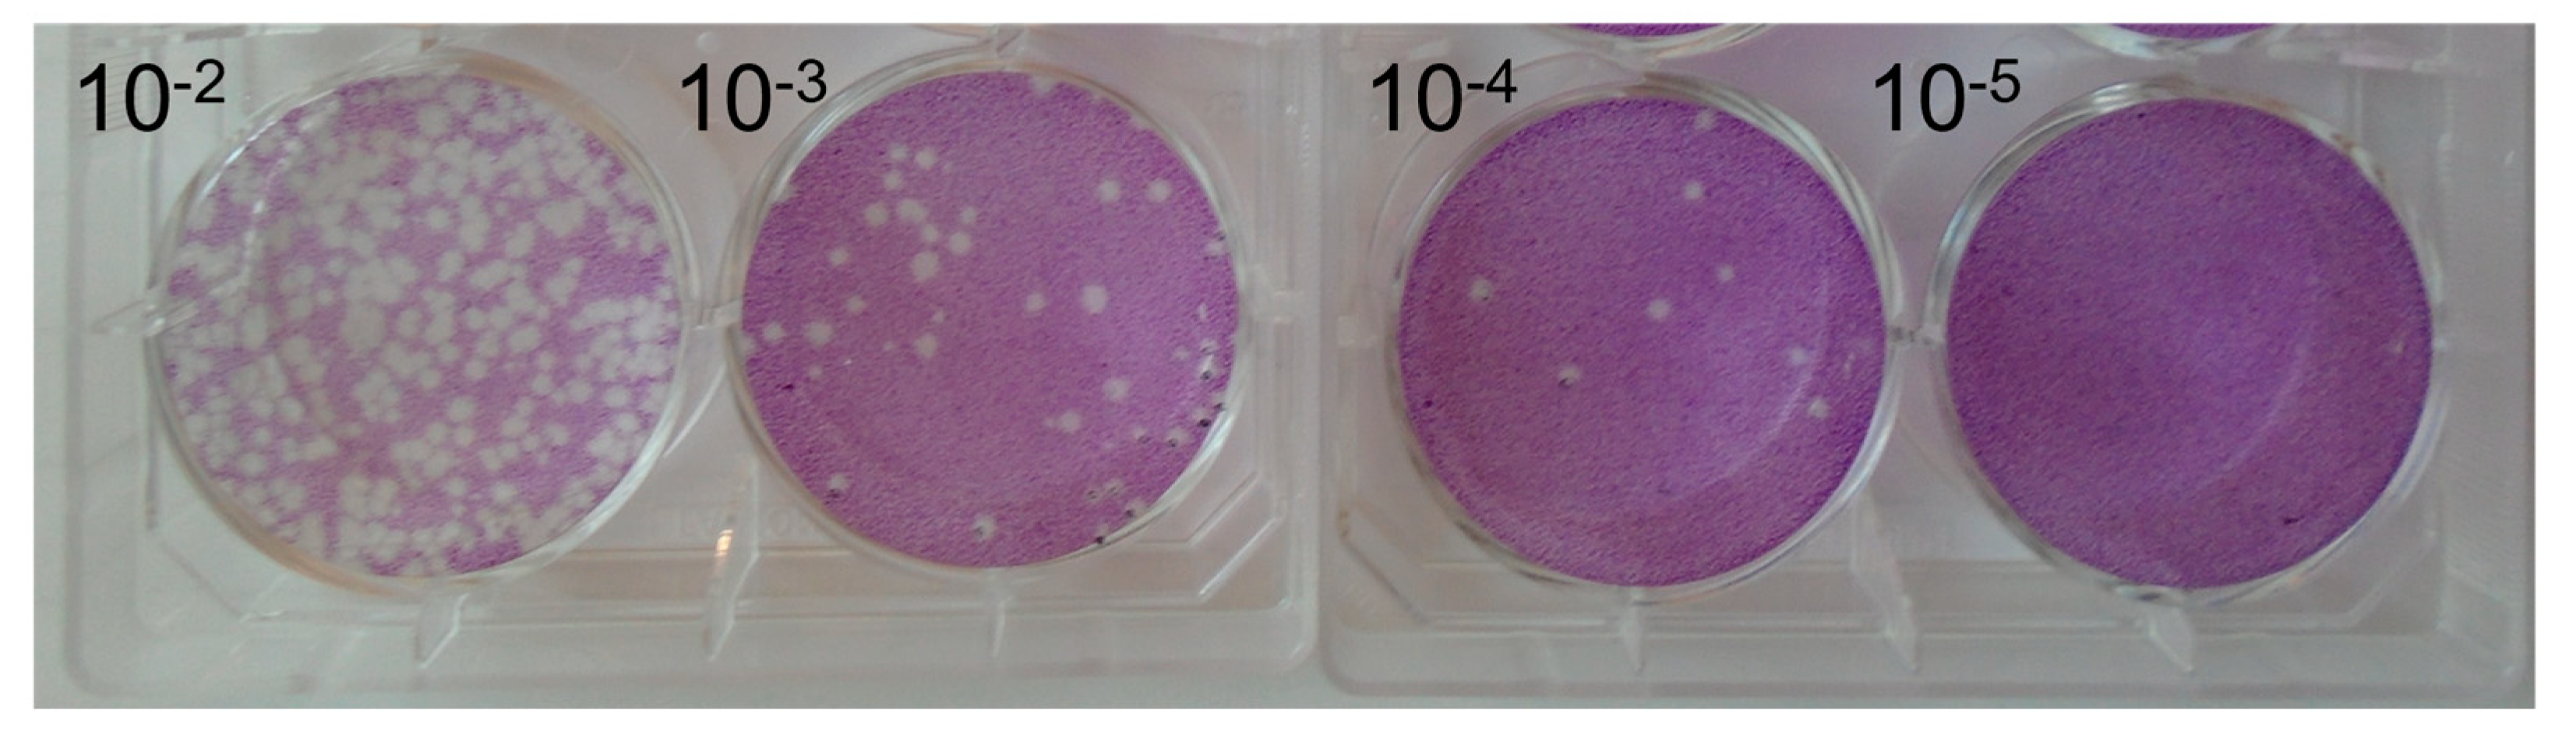
Pathogens 12 01022 g002

The Effect of Temperature on the Stability of African Swine Fever Virus BA71V Isolate in Environmental Water Samples
Abstract
1. Introduction
2. Materials and Methods
2.1. Propagation of BA71V Virus Stocks
2.2. Sampling of Environmental Water
2.3. Titration of Virus Stocks
2.4. Water Inactivation
3. Results
4. Discussion
Supplementary Materials
Author Contributions
Funding
Institutional Review Board Statement
Informed Consent Statement
Data Availability Statement
Acknowledgments
Conflicts of Interest
References
- Alonso, C.; Borca, M.; Dixon, L.; Revilla, Y.; Rodriguez, F.; Escribano, J.M.; ICTV Report Consortium. ICTV Virus Taxonomy Profile Asfarviridae. J. Gen. Virol. 2018, 99, 613–614. [Google Scholar] [CrossRef] [PubMed]
- Blome, S.; Franzke, K.; Beer, M. African swine fever–A review of current knowledge. Virus Res. 2020, 287, 198099. [Google Scholar] [CrossRef]
- Montgomery, R.E. On A Form of Swine Fever Occurring in British East Africa (Kenya Colony). J. Comp. Pathol. Ther. 1921, 34, 159–191. [Google Scholar] [CrossRef]
- Plowright, W.; Parker, J.; Peirce, M.A. African Swine Fever Virus in Ticks (Ornithodoros moubata, Murray) collected from Animal Burrows in Tanzania. Nature 1969, 221, 1071–1073. [Google Scholar] [CrossRef] [PubMed]
- Rowlands, R.J.; Michaud, V.; Heath, L.; Hutchings, G.; Oura, C.; Vosloo, W.; Dwarka, R.; Onashvili, T.; Albina, E.; Dixon, L.K. African Swine Fever Virus Isolate, Georgia, 2007. Emerg. Infect. Dis. 2008, 14, 1870–1874. [Google Scholar] [CrossRef]
- Ma, J.; Chen, H.; Gao, X.; Xiao, J.; Wang, H. African swine fever emerging in China: Distribution characteristics and high-risk areas. Prev. Vet. Med. 2020, 175, 104861. [Google Scholar] [CrossRef]
- Zhou, X.; Li, N.; Luo, Y.; Liu, Y.; Miao, F.; Chen, T.; Zhang, S.; Cao, P.; Li, X.; Tian, K.; et al. Emergence of African Swine Fever in China, 2018. Transbound. Emerg. Dis. 2018, 65, 1482–1484. [Google Scholar] [CrossRef]
- Sánchez-Cordón, P.J.; Montoya, M.; Reis, A.L.; Dixon, L.K. African swine fever: A re-emerging viral disease threatening the global pig industry. Vet. J. 2018, 233, 41–48. [Google Scholar] [CrossRef]
- Sindryakova, I.; Morgunov, Y.; Chichikin, A.; Gazaev, I.; Kudryashov, D.; Tsybanov, S. The influence of temperature on the Russian isolate of African swine fever virus in pork products and feed with extrapolation to natural conditions. Sel'skokhozyaistvennaya Biol. 2016, 51, 467–474. [Google Scholar] [CrossRef]
- Dee, S.A.; Bauermann, F.V.; Niederwerder, M.C.; Singrey, A.; Clement, T.; de Lima, M.; Long, C.; Patterson, G.; Sheahan, M.A.; Stoian, A.M.M.; et al. Survival of viral pathogens in animal feed ingredients under transboundary shipping models. PLoS ONE 2018, 13, e0194509. [Google Scholar] [CrossRef]
- Mazur-Panasiuk, N.; Żmudzki, J.; Woźniakowski, G. African swine fever virus–persistence in different environmental conditions and the possibility of its indirect transmission. J. Vet. Res. 2019, 63, 303–310. [Google Scholar] [CrossRef]
- Carlson, J.; Fischer, M.; Zani, L.; Eschbaumer, M.; Fuchs, W.; Mettenleiter, T.; Beer, M.; Blome, S. Stability of African Swine Fever Virus in Soil and Options to Mitigate the Potential Transmission Risk. Pathogens 2020, 9, 977. [Google Scholar] [CrossRef]
- Fischer, M.; Hühr, J.; Blome, S.; Conraths, F.J.; Probst, C. Stability of African Swine Fever Virus in Carcasses of Domestic Pigs and Wild Boar Experimentally Infected with the ASFV “Estonia 2014” Isolate. Viruses 2020, 12, 1118. [Google Scholar] [CrossRef]
- Mazur-Panasiuk, N.; Woźniakowski, G. Natural inactivation of African swine fever virus in tissues: Influence of temperature and environmental conditions on virus survival. Vet. Microbiol. 2020, 242, 108609. [Google Scholar] [CrossRef] [PubMed]
- Prodelalova, J.; Kavanova, L.; Salat, J.; Moutelikova, R.; Kobzova, S.; Krasna, M.; Vasickova, P.; Simek, B.; Vaclavek, P. Experimental Evidence of the Long-Term Survival of Infective African Swine Fever Virus Strain Ba71V in Soil under Different Conditions. Pathogens 2022, 11, 648. [Google Scholar] [CrossRef]
- Niederwerder, M.C.; Khanal, P.; Foland, T.; Constance, L.A.; Stoian, A.M.M.; Deavours, A.; Haase, K.; Cino-Ozuna, A.G. Stability of African swine fever virus in feed during environmental storage. Transbound. Emerg. Dis. 2022, 69, 3216–3224. [Google Scholar] [CrossRef] [PubMed]
- Ungur, A.; Cazan, C.D.; Panait, L.C.; Coroian, M.; Cătoi, C. What Is the Real Influence of Climatic and Environmental Factors in the Outbreaks of African Swine Fever? Animals 2022, 12, 781. [Google Scholar] [CrossRef]
- Niederwerder, M.C.; Stoian, A.M.M.; Rowland, R.R.R.; Dritz, S.S.; Petrovan, V.; Constance, L.A.; Gebhardt, J.T.; Olcha, M.; Jones, C.K.; Woodworth, J.C.; et al. Infectious Dose of African Swine Fever Virus When Consumed Naturally in Liquid or Feed. Emerg. Infect. Dis. 2019, 25, 891–897. [Google Scholar] [CrossRef] [PubMed]
- Rodríguez, J.M.; Moreno, L.T.; Alejo, A.; Lacasta, A.; Rodríguez, F.; Salas, M.L. Genome Sequence of African Swine Fever Virus BA71, the Virulent Parental Strain of the Nonpathogenic and Tissue-Culture Adapted BA71V. PLoS ONE 2015, 10, e0142889. [Google Scholar] [CrossRef]
- Yáñez, R.J.; Rodríguez, J.M.; Nogal, M.L.; Yuste, L.; Enríquez, C.; Rodriguez, J.F.; Viñuela, E. Analysis of the Complete Nucleotide Sequence of African Swine Fever Virus. Virology 1995, 208, 249–278. [Google Scholar] [CrossRef]
- Enjuanes, L.; Carrascosa, A.L.; Moreno, M.A.; Viñuela, E. Titration of African Swine Fever (ASF) Virus. J. Gen. Virol. 1976, 32, 471–477. [Google Scholar] [CrossRef] [PubMed]
- Bowes, M.J.; Armstrong, L.K.; Harman, S.A.; Wickham, H.D.; Nicholls, D.J.E.; Scarlett, P.M.; Roberts, C.; Jarvie, H.P.; Old, G.H.; Gozzard, E.; et al. Weekly water quality monitoring data for the River Thames (UK) and its major tributaries (2009–2013): The Thames Initiative research platform. Earth Syst. Sci. Data 2018, 10, 1637–1653. [Google Scholar] [CrossRef]
- Frost, L.; Batten, C. African Swine Fever Virus Plaque Assay and Disinfectant Testing. Methods Mol. Biol. 2022, 2503, 187–194. [Google Scholar]
- APHA. The Pirbright Institute Disinfectant Efficacy Tests. 2021. Available online: https://assets.publishing.service.gov.uk/government/uploads/system/uploads/attachment_data/file/1041676/disinfectants-efficacy-tests.pdf (accessed on 18 July 2023).
- Tiwari, S.; Dhakal, T.; Kim, T.-S.; Lee, D.-H.; Jang, G.-S.; Oh, Y. Climate Change Influences the Spread of African Swine Fever Virus. Vet. Sci. 2022, 9, 606. [Google Scholar] [CrossRef] [PubMed]

| Sampling Location Code | Sample Number |
|---|---|
| TC2 | S8 |
| TC3 | S10 |
| TC11 | S2 |
| TC12 | S4 |
| TC15 | S3 |
| TC16 | S9 |
| TC18 | S11 |
| TC20 | S1 |
| TC21 | S7 |
| TC22 | S5 |
| TC28 | S6 |
Disclaimer/Publisher’s Note: The statements, opinions and data contained in all publications are solely those of the individual author(s) and contributor(s) and not of MDPI and/or the editor(s). MDPI and/or the editor(s) disclaim responsibility for any injury to people or property resulting from any ideas, methods, instructions or products referred to in the content. |
© 2023 by the authors. Licensee MDPI, Basel, Switzerland. This article is an open access article distributed under the terms and conditions of the Creative Commons Attribution (CC BY) license (https://creativecommons.org/licenses/by/4.0/).
Share and Cite
Loundras, E.-A.; Netherton, C.L.; Flannery, J.; Bowes, M.J.; Dixon, L.; Batten, C. The Effect of Temperature on the Stability of African Swine Fever Virus BA71V Isolate in Environmental Water Samples. Pathogens 2023, 12, 1022. https://doi.org/10.3390/pathogens12081022
Loundras E-A, Netherton CL, Flannery J, Bowes MJ, Dixon L, Batten C. The Effect of Temperature on the Stability of African Swine Fever Virus BA71V Isolate in Environmental Water Samples. Pathogens. 2023; 12(8):1022. https://doi.org/10.3390/pathogens12081022
Chicago/Turabian StyleLoundras, Eleni-Anna, Christopher L. Netherton, John Flannery, Michael J. Bowes, Linda Dixon, and Carrie Batten. 2023. "The Effect of Temperature on the Stability of African Swine Fever Virus BA71V Isolate in Environmental Water Samples" Pathogens 12, no. 8: 1022. https://doi.org/10.3390/pathogens12081022
APA StyleLoundras, E.-A., Netherton, C. L., Flannery, J., Bowes, M. J., Dixon, L., & Batten, C. (2023). The Effect of Temperature on the Stability of African Swine Fever Virus BA71V Isolate in Environmental Water Samples. Pathogens, 12(8), 1022. https://doi.org/10.3390/pathogens12081022

